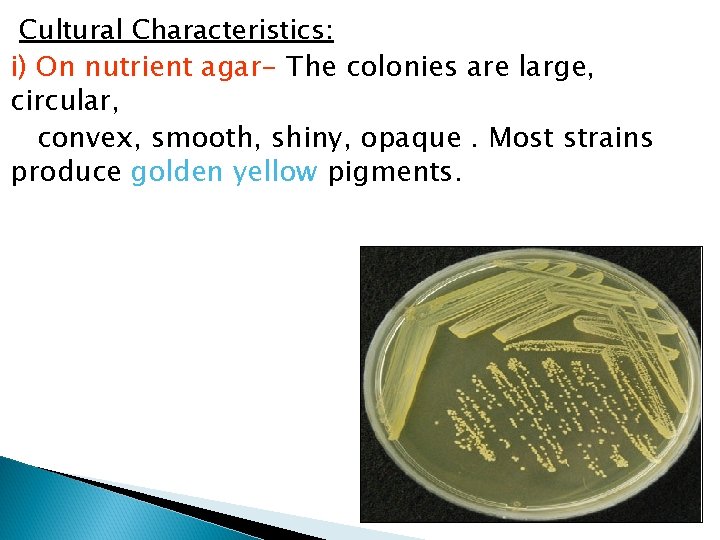
Cultural Characteristics: i) On nutrient agar- The colonies are large, circular, convex, smooth, shiny,

Part 1 Dr Salma Staphylococci are Gram positive

- Slides: 37
Part 1 Dr. Salma
Staphylococci are : -Gram positive cocci, -Occur in grape like clusters, -They are non motile and non sporing. -A few strains possess capsules -Produce pigments
Cultural Characteristics: i) On nutrient agar- The colonies are large, circular, convex, smooth, shiny, opaque. Most strains produce golden yellow pigments.
ii) On Mac. Conkey’s agar- The colonies are small & pink in colour. iii) On blood agar- Most strains produce βhaemolytic colonies.
CLASSIFICATION: A) Based on coagulase production: 1. Coagulase positive: Eg- S. aureus 2. Coagulase negative: Eg- S. epidermidis S. saprophyticus B) Based on pathogenicity: 1. Common pathogen: Eg- S. aureus 2. Opportunistic pathogens: Eg- S. epidermidis , S. saprophyticus 3. Non pathogen: Eg- S. homonis
S. aureus S. epidermidis Skin infections Prosthetic Infection Osteomyelitis Food poisoning Toxic shock syndrome Pneumonia Acute endocarditis Infective arthritis Necrotizing fasciitis Sepsis UTI especially in patient with catheter & low immunity. S. saprophyticus UTI in sexually active females Non Gonococcal Urethritis in males.
CULTURE: Media used : i) Non selective media: Nutrient agar, Blood agar, Mac. Conkey’s agar. ii) Selective media: Salt-milk agar,
s. aureus s. epidermidis
MANNITOL SALT AGAR Na. Cl 7. 5% selective Mannitol differential Staphylococcus aureus can ferment mannitol, so the selective media used to isolate Staphylococcus aureus especially from nasal carriage is (Mannitol Salt Agar)
Biochemical tests: Coagulase test: DETECT the ability of S. aureus to clot blood plasma (fibrinogen fibrin). Slide method Tube method Catalase test: To differentiate between Staph. & Strepto.
Biochemical reactions: 1) Catalase test- Positive.
2) Coagulase testi) Slide coagulase test- Positive. ii) Tube coagulase test- Positive. SLIDE COAGULASE TEST TUBE COAGULASE TEST
3) Reduces nitrate to nitrite. 4) Ferments mannitol anaerobically with acid only. 5) Urea hydrolysis test- Positive. 6) Gelatin liquefaction test- Positive. 7) Produces Lipase. 8) Produces Phosphatase. 9) Produces nuclease.
PATHOGENICITY: Source of infection: A) Exogenous: patients or carriers B) Endogenous: From colonized site Mode of transmission: A) Contact: direct or indirect( through fomites) B) Inhalation of air borne droplets
Virulence factors: These include A) Cell associated factors B) Extracellular factors
A) CELL ASSOCIATED FACTORS: a) Cell associated polymers b) Cell surface proteins a) CELL ASSOCIATED POLYMERS 1. Cell wall polysaccharide 2. Teichoic acid 3. Capsular polysaccharide b) CELL SURFACE PROTEINS: 1. Protein A 2. Clumping factor (bound coagulase)
Structure of Staphylococcal cell wall
Virulence factors of Staphylococcus aureus III.
B) EXTRACELLULAR FACTORS a) Enzymes b) Toxins
a) Enzymes: 1. Free coagulase 2. Catalase 3. Lipase 4. Hyaluronidase 5. DNAase 6. Thermonuclease 7. Staphylokinase (Fibrinolysin) 8. Phosphatase
b) Toxins: 1. Cytolytic toxins i) Haemolysins Alpha haemolysin Beta haemolysin Gamma haemolysin Delta haemolysin ii) Leucocidin (Panton-Valentine toxin) 2. Enterotoxin 3. Toxic shock syndrome toxin (TSST) 4. Exfoliative (epidermolytic toxin).
Disease: Diseases produced by Staphylococcus aureus is studied under 2 groups: A) Infections B) Intoxications
A) INFECTIONS: Mechanism of pathogenesis: Cocci gain access to damaged skin, mucosal or tissue site Colonize by adhering to cells or extracellular matrix Evade the host defense mechanisms and multiply Cause tissue damage
Common Staphylococcal infections are: 1) Skin and soft tissue: Folliculitis, furuncle (boil), carbuncle, styes, abscess, wound infections, impetigo, and less often cellulitis. Folliculitis
Furuncle (boil) Carbuncle
Styes Abscess
Impetigo Wound infection Paronychia Cellulitis
2) Musculoskeletal: Osteomyelitis, arthritis. 3) Respiratory: Tonsillitis, pharyngitis, sinusitis, otitis, bronchopneumonia, lung abscess, rarely pneumonia.
4) Central nervous system: Abscess, meningitis, . 5) Endovascular: Bacteremia, septicemia, pyemia, endocarditis, Urinary tract infection.
B) INTOXICATIOINS: The disease is caused by the bacterial exotoxins, which are produced either in the infected host or preformed in vitro. There are 3 types. Food poisoning Toxic shock syndrome Staphylococcal scalded skin syndrome
1) Food poisoning: Enterotoxin is responsible for manifestations of staphylococcal food poisoning. Eight types of enterotoxin are currently known, named A, B, C 1 -3, D, E, and H. It usually occurs when preformed toxin is ingested with contaminated food. The toxin acts directly on the autonomic nervous system to cause the illness, rather than gut mucosa.
The common food items responsible are - milk and milk products, meat, fish and ice cream. Source of infection- food handler who is a carrier. Incubation period- 2 to 6 hours. Clinical symptoms- nausea, vomiting and diarrhoea. The illness is usually self limited, with recovery in a day or so.
2) Staphylococcal Toxic shock syndrome (STSS): STSS is associated with infection of mucosal or sequestered sites by TSST( formerly known as enterotoxin type F) producing S. aureus. It is fatal multisystem disease presenting with fever, hypotension, myalgia, vomiting, diarrhoea, mucosal hyperemia and erythematous rash which desquamates subsequently.
3) Staphylococcal scalded skin syndrome (SSSS): Exfoliative toxin produced by S. aureus is responsible for this. It is a skin disease in which outer layer of epidermis gets separated from the underlying tissues.
THANK YOU